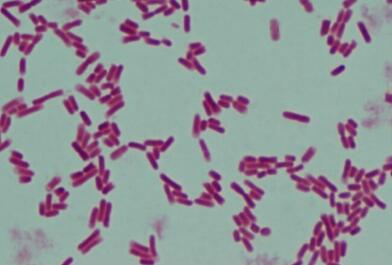
顯微鏡下的大腸桿菌

顯微鏡下的大腸桿菌
-
大腸桿菌(E. coli)是一種常見于土地和水等各種生態(tài)系統(tǒng)中的細(xì)菌。
-
大多數(shù)大腸桿菌菌株是無害的,但已知某些菌株會引起腹瀉,甚至引起UTI。
-
大腸桿菌被普遍認(rèn)為是研究不同細(xì)菌的標(biāo)準(zhǔn)。
-
由于大腸桿菌是一種能運動的生物,因此直接觀察大腸桿菌而不染色是有益的。
-
大腸桿菌是原核生物,沒有膜結(jié)合核,具有原始細(xì)胞器。
-
大腸桿菌是一種細(xì)菌,具有帶圓形邊緣的細(xì)長結(jié)構(gòu)。

圖:在顯微鏡下的大腸桿菌。
吊滴法
-
執(zhí)行該技術(shù)以觀察生物體的運動。
-
通過這種方法,可以觀察到活生物體,從而可以更逼真的觀察生物體。
-
可以用這種技術(shù)觀察生物體的結(jié)構(gòu),在這種技術(shù)中,大腸桿菌被視為鏈狀排列的芽孢桿菌。
-
通過這種方法看不到內(nèi)部結(jié)構(gòu)和細(xì)胞器,因為有機體本身是無色的。
-
然而,可以觀察生物體的運動性,同時改變位置而不顯示布朗運動,而沿不同的方向運動。
簡單染色
-
通常執(zhí)行此方法以簡單地檢測和觀察大腸桿菌。
-
在此,生物體被明顯的彩色污漬染色,這導(dǎo)致細(xì)菌的整個表面被該顏色染色。
-
大腸桿菌被視為棒狀生物,大小范圍為1-2 µm。細(xì)菌大多以鏈狀出現(xiàn)。
-
但是,某些細(xì)菌作為單個單位單獨存在。
-
在更高功率的顯微鏡下,可以觀察生物體內(nèi)的內(nèi)部細(xì)胞成分。
-
然而,對于細(xì)胞器的更詳細(xì)的結(jié)構(gòu),將對內(nèi)部細(xì)胞器進行單獨染色。
克染色
-
革蘭氏染色后,大腸桿菌在復(fù)合顯微鏡下呈粉紅色。
-
這表明細(xì)菌是革蘭氏陰性菌,并且在細(xì)胞膜上有一層由磷脂和脂多糖組成的附加層。
-
在像掃描透射電子顯微鏡這樣的高功率顯微鏡下,甚至可以染色并觀察細(xì)胞器的詳細(xì)結(jié)構(gòu)。
-
原子核在中心沒有較大膜狀,但在中心出現(xiàn)了一個大黑點。
-
細(xì)胞質(zhì)也被染色,揭示出其他結(jié)構(gòu),如小點或長絲狀結(jié)構(gòu)。
-
在細(xì)胞膜的表面,可見長的絲狀結(jié)構(gòu),稱為鞭毛。
国产成人精品免费视频网站,91www在线观看,日韩久久精品,久久久久久国产
白嫩情侣偷拍呻吟刺激|
国产91丝袜美女在线播放|
99re久久精品国产|
国产精品视频一区二区在线观看|
少妇伦子伦精品无吗|
成人无码av片在线观看|
中出视频在线观看|
午夜免费福利影院|
亚洲成人av免费观看|
国产视频不卡在线|
在线 丝袜 欧美 日韩 制服|
中文字幕一区二区三区人妻在线视频
|
色欲一区二区三区精品a片|
亚洲制服丝袜在线播放|
日本精品一二三区|
337p日本欧洲亚洲大胆张筱雨
|
蜜桃av免费在线观看|
小早川怜子久久精品中文字幕|
日本少妇色视频|
人妻av无码一区二区三区|
熟女俱乐部一区二区|
中文字幕成人动漫|
gv天堂gv无码男同在线观看|
免费在线观看你懂的|
国产成人无码精品久久二区三|
无码人妻aⅴ一区二区三区69岛|
国产又黄又粗视频|
精品在线观看一区|
四川一级毛毛片|
日本性生活一级片|
国产精品扒开腿做爽爽|
人人妻人人澡人人爽|
艳妇荡乳欲伦69影片|
性感美女一区二区三区|
精品国产无码在线观看|
五月综合色婷婷|
久久国产免费视频|
亚洲码无人客一区二区三区|
国产传媒免费在线观看|
人妻丰满熟妇av无码久久洗澡|
亚洲综合欧美综合|
国产精品嫩草69影院|
国产伦精品一区二区三区精品|
国产又爽又黄无码无遮挡在线观看|
蜜桃av免费观看|
欧美熟妇精品一区二区|
人妻熟人中文字幕一区二区|
97精品人人妻人人|
精品国产精品国产精品|
欧美多人猛交狂配|
色综合久久久无码中文字幕波多|
欧美特黄一区二区三区|
极品白嫩少妇无套内谢|
国产视频123区|
亚洲综合自拍网|
亚洲AV无码久久精品国产一区|
国产一二三四区在线|
久久久久9999|
av漫画在线观看|
国产大学生自拍|
国产性生活大片|
99久久久免费精品|
亚欧精品视频一区二区三区|
中文字幕一区二区三区人妻电影|
japanese在线观看|
精品国产一二区|
三级影片在线看|
少妇高潮惨叫久久久久|
中文字幕人妻一区二区|
熟妇人妻久久中文字幕|
日本wwwwwww|
9.1在线观看免费|
亚洲精品无码一区二区|
日本人妻一区二区三区|
www.美色吧.com|
88av在线播放|
亚洲AV无码国产精品|
欧美图片一区二区|
天天操天天舔天天射|
国产又粗又猛又爽又黄的视频小说|
日韩av片在线|
911国产在线|
成年人性生活视频|
艳妇乳肉亭妇荡乳av|
日本国产在线视频|
国产艳俗歌舞表演hd|
国产在线观看h|
亚洲熟女毛茸茸|
久久久精品少妇|
精品人妻一区二区乱码|
国产精品成人99一区无码|
最新中文字幕视频|
亚洲第一视频区|
国产午夜手机精彩视频|
中文字幕无人区二|
日韩aaaaa|
长河落日免费高清观看|
亚洲精品鲁一鲁一区二区三区|
免费中文字幕av|
欧美视频www|
国产肉体xxxx裸体784大胆|
国产美女永久免费无遮挡|
精品一区在线观看视频|
www.狠狠爱|
在线观看你懂的视频|
实拍女处破www免费看|
国产一二三区精品|
久久亚洲AV成人无码国产野外|
最新日韩免费视频|
性欧美丰满熟妇xxxx性久久久|
欧美色视频一区二区三区在线观看|
波多野结衣加勒比|
男插女视频网站|
国产黄色小视频网站|
在线观看日韩精品视频|
日韩在线观看视频一区二区|
国产男女猛烈无遮挡a片漫画
|
国产激情视频网站|
手机在线中文字幕|
午夜久久久久久久|
全网免费在线播放视频入口|
亚洲av毛片基地|
免费观看a级片|
欧美色图亚洲激情|
7788色淫网站小说|
亚洲欧美日韩色|
国产精品日日摸夜夜爽|
√天堂中文官网8在线|
亚洲成人黄色av|
亚洲理论片在线观看|
国产黄色网址在线观看|
中文字幕一区二区人妻电影丶|
中文写幕一区二区三区免费观成熟|
a一级免费视频|
日韩欧美国产成人精品免费|
中日韩精品一区二区三区|
草视频在线观看|
伊人久久久久久久久|
aaa黄色大片|
无码一区二区精品|
国产十八熟妇av成人一区|
国产又粗又猛又爽又黄|
男生和女生一起差差差视频|
538精品在线视频|
国产大学生av|
视频免费在线观看|
国产麻豆天美果冻无码视频
|
懂色av懂色av粉嫩av|
chinese全程对白|
精品一区在线观看视频|
97免费公开视频|
www.88av|
亚洲AV成人无码网站天堂久久|
亚洲人与黑人屁股眼交|
波多野结衣办公室双飞|
欧美 日本 国产|
18禁裸乳无遮挡啪啪无码免费|
青娱乐国产视频|
无套白嫩进入乌克兰美女|
草草地址线路①屁屁影院成人|
www.涩涩爱|
久久国产精品国语对白|
日b视频在线观看|
性欧美精品中出|
日本成人在线免费观看|
精品国产av色一区二区深夜久久|
永久免费毛片在线观看|
亚洲av无一区二区三区久久|
中文字幕 亚洲一区|
久艹在线观看视频|
男人的天堂影院|
国产黄色片在线|
国产黑丝在线观看|
老司机深夜福利网站|
亚洲少妇18p|
午夜爽爽爽男女免费观看|
欧美无人区码suv|
搜索黄色一级片|
国产在线观看h|
精品无码国产一区二区三区51安|
登山的目的在线|
性欧美成人播放77777|
国产日产精品一区二区三区的介绍|
欧产日产国产精品98|
日本成人在线免费观看|
chinese全程对白|
丁香六月激情综合|
亚洲国产天堂av|
亚洲 小说 欧美 激情 另类|
亚洲色偷偷色噜噜狠狠99网|
九九热久久免费视频|
最新中文字幕av|
国产精品av久久久久久无|
av直播在线观看|
久久人妻一区二区|
在线精品视频播放|
国产黑丝一区二区|
国产精品久久久免费观看|
国产毛片毛片毛片毛片毛片毛片|
亚洲国产欧美日韩在线|